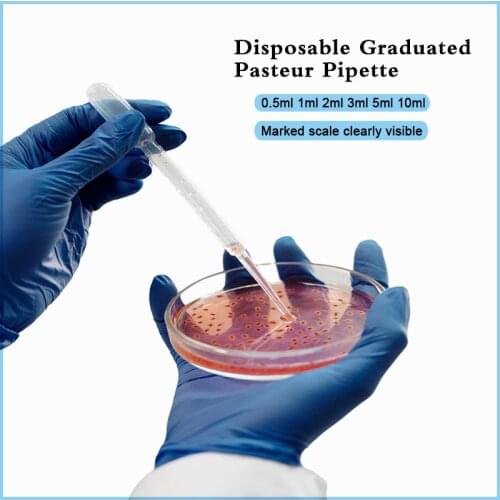
Pasteur Pipette 0.5ml 1ml 2ml 3ml 5ml 10ml Disposable Graduated LDPE Plastic Dropper Urine Straw Lab School Tools Pasteur Straw

New IKEME stationery
204 Stationery By IKEME Brand Found. Average cost items in Stationery list is $9. IKEME brand products are 461% more expensive than others.
Price: $18.07
IKEME Store
Price: $234
Old Price: $260IKEME Store
Price: $320.77
IKEME Store
Price: $341.11
IKEME Store
Price: $126.1
IKEME Store
Price: $108.1
Old Price: $115IKEME Store
Price: $526.34
IKEME Store
Price: $192.77
IKEME Store
Price: $204.22
IKEME Store
Price: $1326.76
IKEME Store
Price: $94
Old Price: $100IKEME Store
Price: $229.94
IKEME Store
Price: $274.2
IKEME Store
Price: $186.78
IKEME Store
Price: $361.29
IKEME Store
Price: $3144.9
IKEME Store
Price: $2.46
IKEME Store
Price: $200
IKEME Store
Price: $151.06
IKEME Store
Price: $1.41
IKEME Store
Price: $29.68
IKEME Store
Price: $137.26
IKEME Store
Price: $30.02
IKEME Store
Price: $300.8
Old Price: $320IKEME Store
Price: $352.47
Old Price: $379IKEME Store
Price: $15.96
IKEME Store
Price: $18.89
Old Price: $20.99IKEME Store
Price: $1076.52
IKEME Store
Price: $339.15
Old Price: $357IKEME Store
Price: $9.11
Old Price: $9.6IKEME Store
Price: $492.7
IKEME Store
Price: $269.1
Old Price: $299IKEME Store
Price: $683.1
Old Price: $759IKEME Store
Price: $23.24
Old Price: $24.99IKEME Store
Price: $44.02
IKEME Store
Price: $98.09
IKEME Store
Price: $11.16
IKEME Store
Price: $44.25
IKEME Store
Price: $3.15
IKEME Store
Price: $179.4
Old Price: $195IKEME Store
Price: $240.43
IKEME Store
Price: $6.86
IKEME Store
Price: $50.41
IKEME Store
Price: $14.68
Old Price: $16.5IKEME Store
Price: $8.47
Old Price: $11IKEME Store
Price: $9.66
IKEME Store
Price: $5844.65
IKEME Store
Price: $18.87
IKEME Store
Price: $28.4
Old Price: $29.9IKEME Store
Price: $92
IKEME Store
Price: $37.79
Old Price: $45IKEME Store
Price: $14.6
Old Price: $20IKEME Store
Price: $440.55
Old Price: $445IKEME Store
Price: $35.72
Old Price: $38IKEME Store
Price: $41.27
Old Price: $43.9IKEME Store
Price: $32.77
Old Price: $34.5IKEME Store
Price: $38.64
Old Price: $46IKEME Store
Price: $5017.72
IKEME Store
Price: $202.1
Old Price: $215IKEME Store